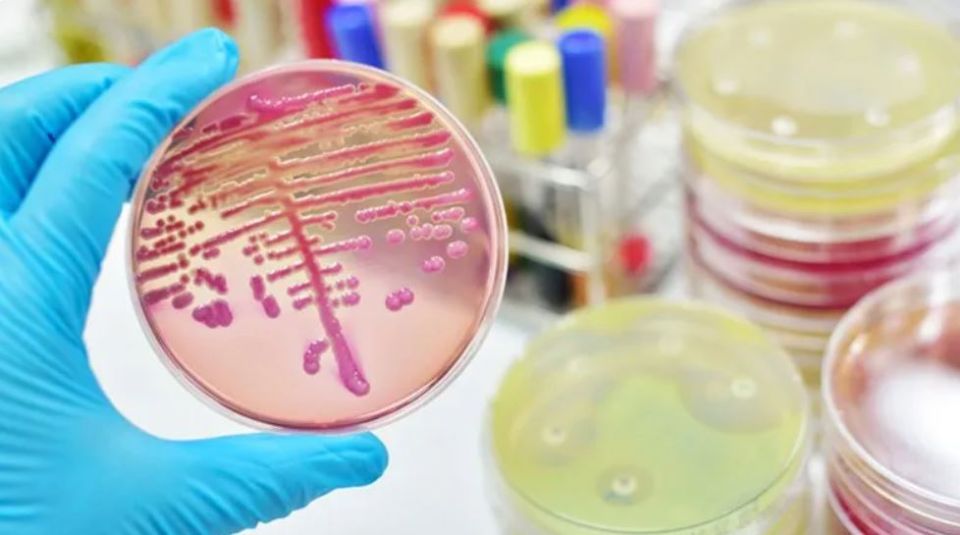
microbiologia

Test per il rilevamento di Streptococco di gruppo A, COVID-19, Influenza e RSV

I nostri test accurati per il rilevamento di Streptococco di gruppo A, COVID-19, Influenza e RSV supportano le decisioni terapeutiche riducendo il numero di prescrizioni inappropriate di antibiotici e limitando il rischio di complicazioni nei pazienti pediatrici. Contattaci per saperene di più.

Laboratorio di Analisi Alhena a Pescara e a Cappelle sul Tavo
L'aggiornamento costante della strumentazione analitica permette di rilasciare risultati sempre più accurati e con tempi di risposta sempre più brevi. Il laboratorio esegue analisi cliniche, genetiche, molecolari, allergologiche, oncologiche, farmacologiche ed endocrinologiche.
I servizi offerti

Analisi e referti in tempi brevi
Laboratorio di Analisi Cliniche Alhena si avvale di appropriata strumentazione scientifica e di un’organizzazione interna estremamente efficace.
È in grado di soddisfare con precisione e competenza la maggioranza delle richieste di analisi di patologia clinica e di consegnare i referti in tempi brevi, anche in giornata.
Il laboratorio è specializzato nell’esecuzione di test allergologici, test immunologici ed esami specifici per l’infertilità. Vengono effettuate analisi del sangue e analisi microbiologiche.
Il nostro Laboratorio Analisi

Struttura efficiente
In ambienti moderni ed accoglienti il personale sanitario del laboratorio esegue quotidianamente un’ampia gamma di analisi su diversi materiali biologici (sangue, essudati, urine…) e si impegna nella massima tempestività delle risposte.
Il laboratorio garantisce la massima pulizia e disinfezione in tutti i locali in cui vengono effettuati i prelievi e le analisi dei campioni, nel pieno rispetto delle normative sanitarie vigenti e a tutela della sicurezza degli utenti e degli operatori.
I nostri Orari
Help desk
Giorni feriali dalle 7:30 alle 13:30.
Orario prelievi
Dal lunedì al sabato dalle ore 7:30 alle ore 10:00.
Ritiro referti
Dal lunedì al sabato dalle ore 11:00 alle ore 13:00.
Dal lunedì al venerdì dalle ore 16:00 alle ore 18:00.
Chiama per informazioni su tutte le tipologie di analisi effettuate dal laboratorio!
SEDE PESCARA
Via Nazionale Adriatica Nord 3
65125 Pescara
SEDE FILIALE
Complesso "Kilometro Lanciato"
Via Vestina a mare
65010 Cappelle sul Tavo (PE)
La prenotazione per l’esame spermiogramma deve essere richiesta telefonicamente
contattando il laboratorio al numero 085 74595